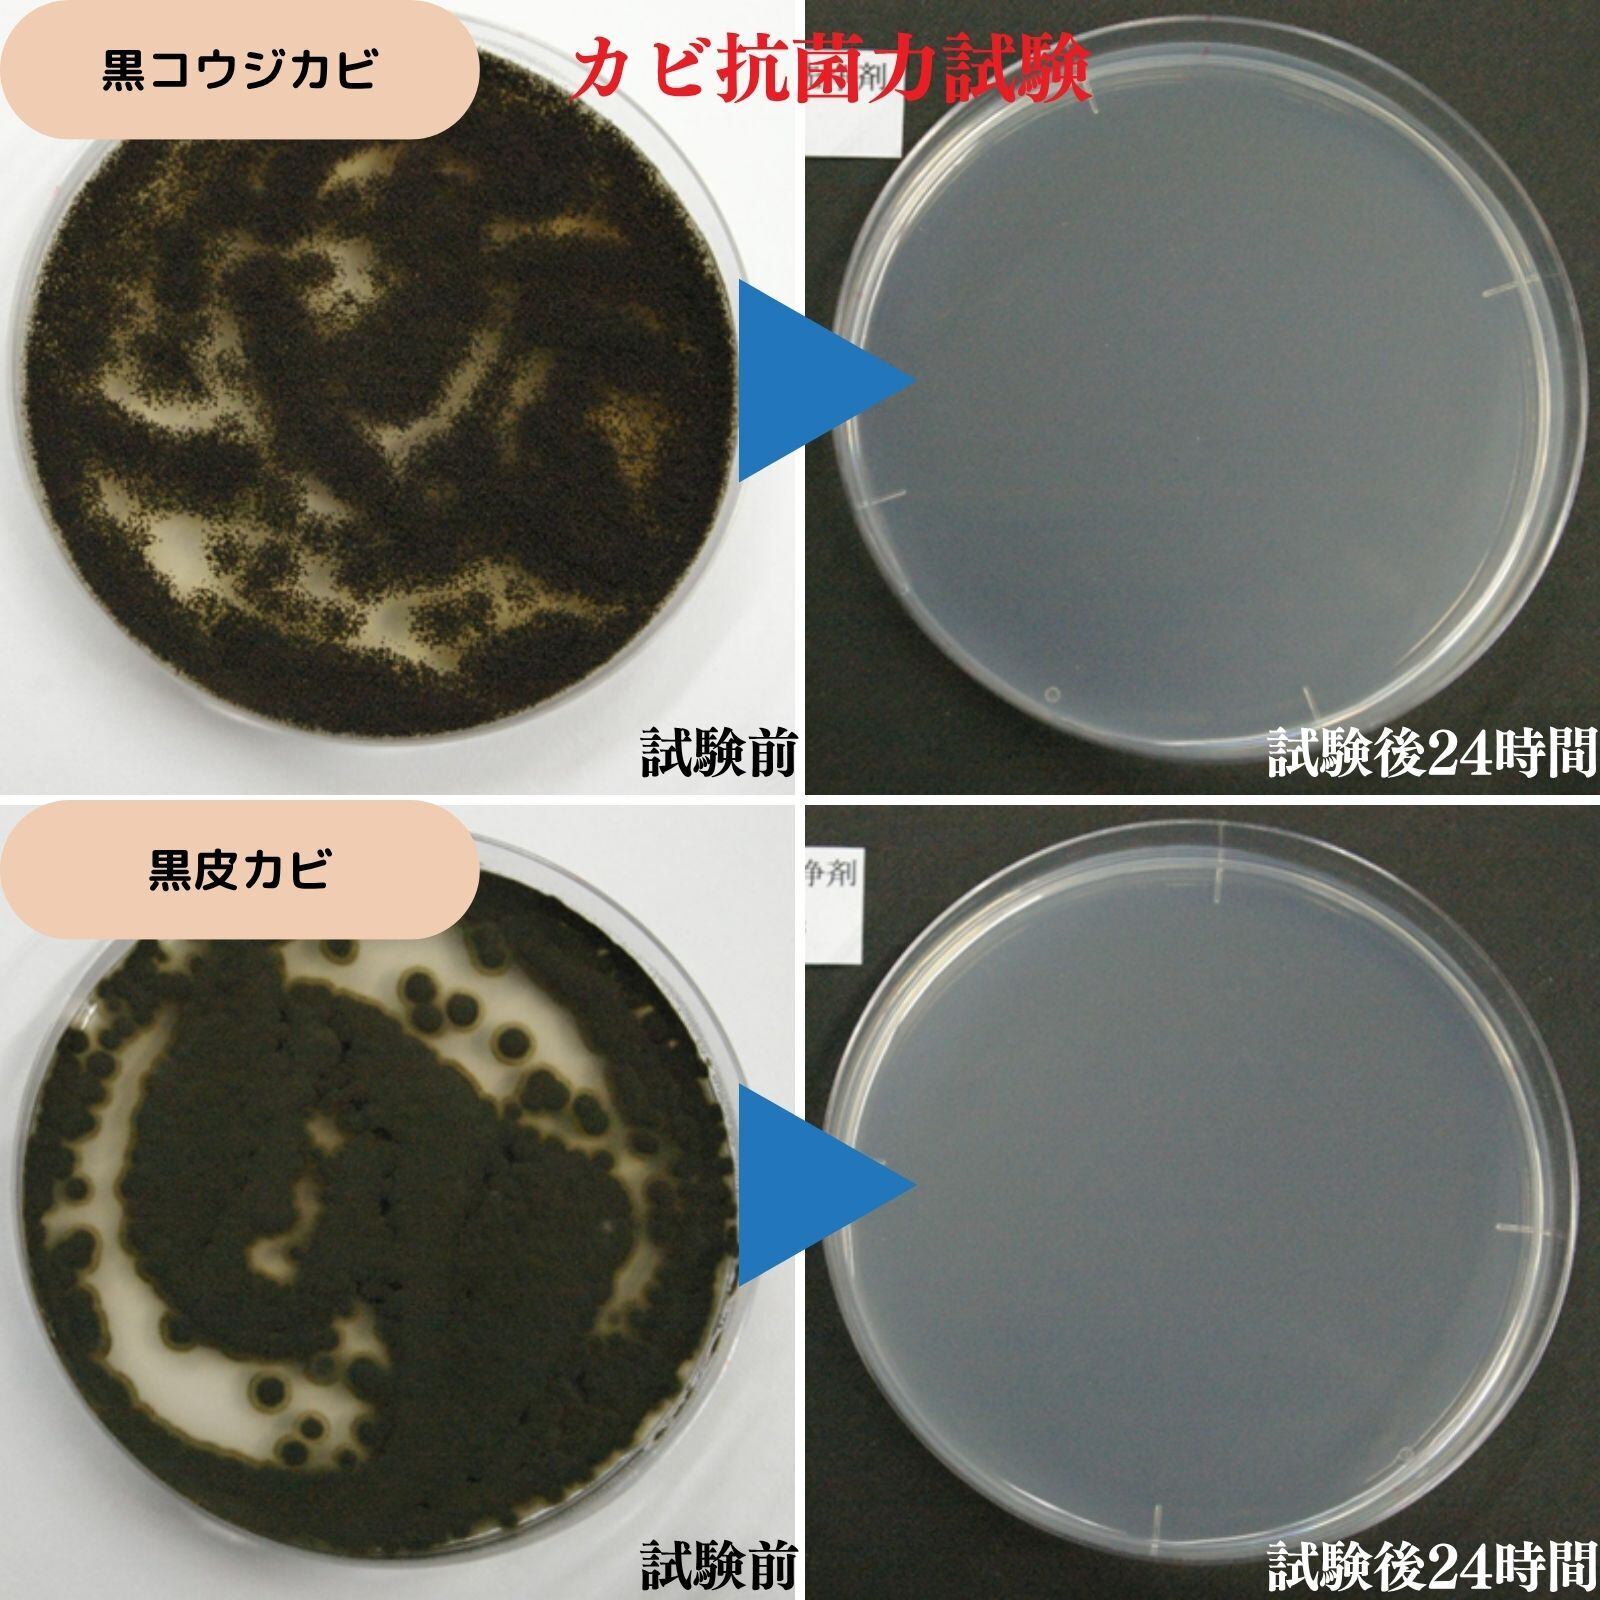

エアコンクリーナーリフレッシュジェット1本
¥2,750
International shipping available
エアコンクリーナーリフレッシュジェット1本
■エアコン清掃これ1本
エアコンの冷却フィンはもちろんフィルター本体ボディーのお手入れにもこれ1本で解決!!
プロの業者さんに頼まないとなかなかお掃除できないエアコン内部フィンの奥の汚れが、しっかりキレイに!
■吹きかけるだけ!簡単にエアコン内部フィンの奥までキレイ!
エアコン1台につき1本を冷却フィンにまんべんなく吹きかけるだけ!
プロの業者さんに頼まないとなかなかお掃除できないエアコン内部フィンの奥の汚れが、しっかりキレイに!
■汚れや臭いをしっかり取り除き・除菌・消臭、おまけに防カビ効果も
除菌・消臭効果の高いグリシンを配合するこによりホコリ・細菌・カビ菌に浸透・分解し、同時に胞子の飛散を抑制、
更にはカビの繁殖を防止します
■素材にも安心
塩素・漂白剤・アルカリ電解水・アルコールを一切使用していない中性剤なので、素材を傷めず、内部アルミフィン・フィルター・吹き出し口まで使用可能。人パッチテスト合格品で、高い安全性を実現!
■確かなエビデンス
公的機関による確かなデーター*有効なカビ・細菌の種類:黒カワカビ/黒コウジカビ/大腸菌/黄色ブドウ球菌/サルモネラ菌/白癬菌等 *全ての菌を除菌できるわけではありません。
■エアコン以外にも使用可能。
(大きなホコリは先に掃除機等で吸ってからのご利用をお勧め致します)
内部フィン(熱交換器)の洗浄は当たり前、エアフィルター・吹き出し口やカバー、
お風呂場の天井隅の、網戸の清掃除菌・冊子の防カビ洗浄にも便利
成分:水・アミノ酸系除菌剤・DMEガス
液性:中性
原産国:日本製
容量:420㎖ 1本
梱包:シュリンク包装
商品寸法:幅6cm(トリガー含む)×高さ25cm 約450g